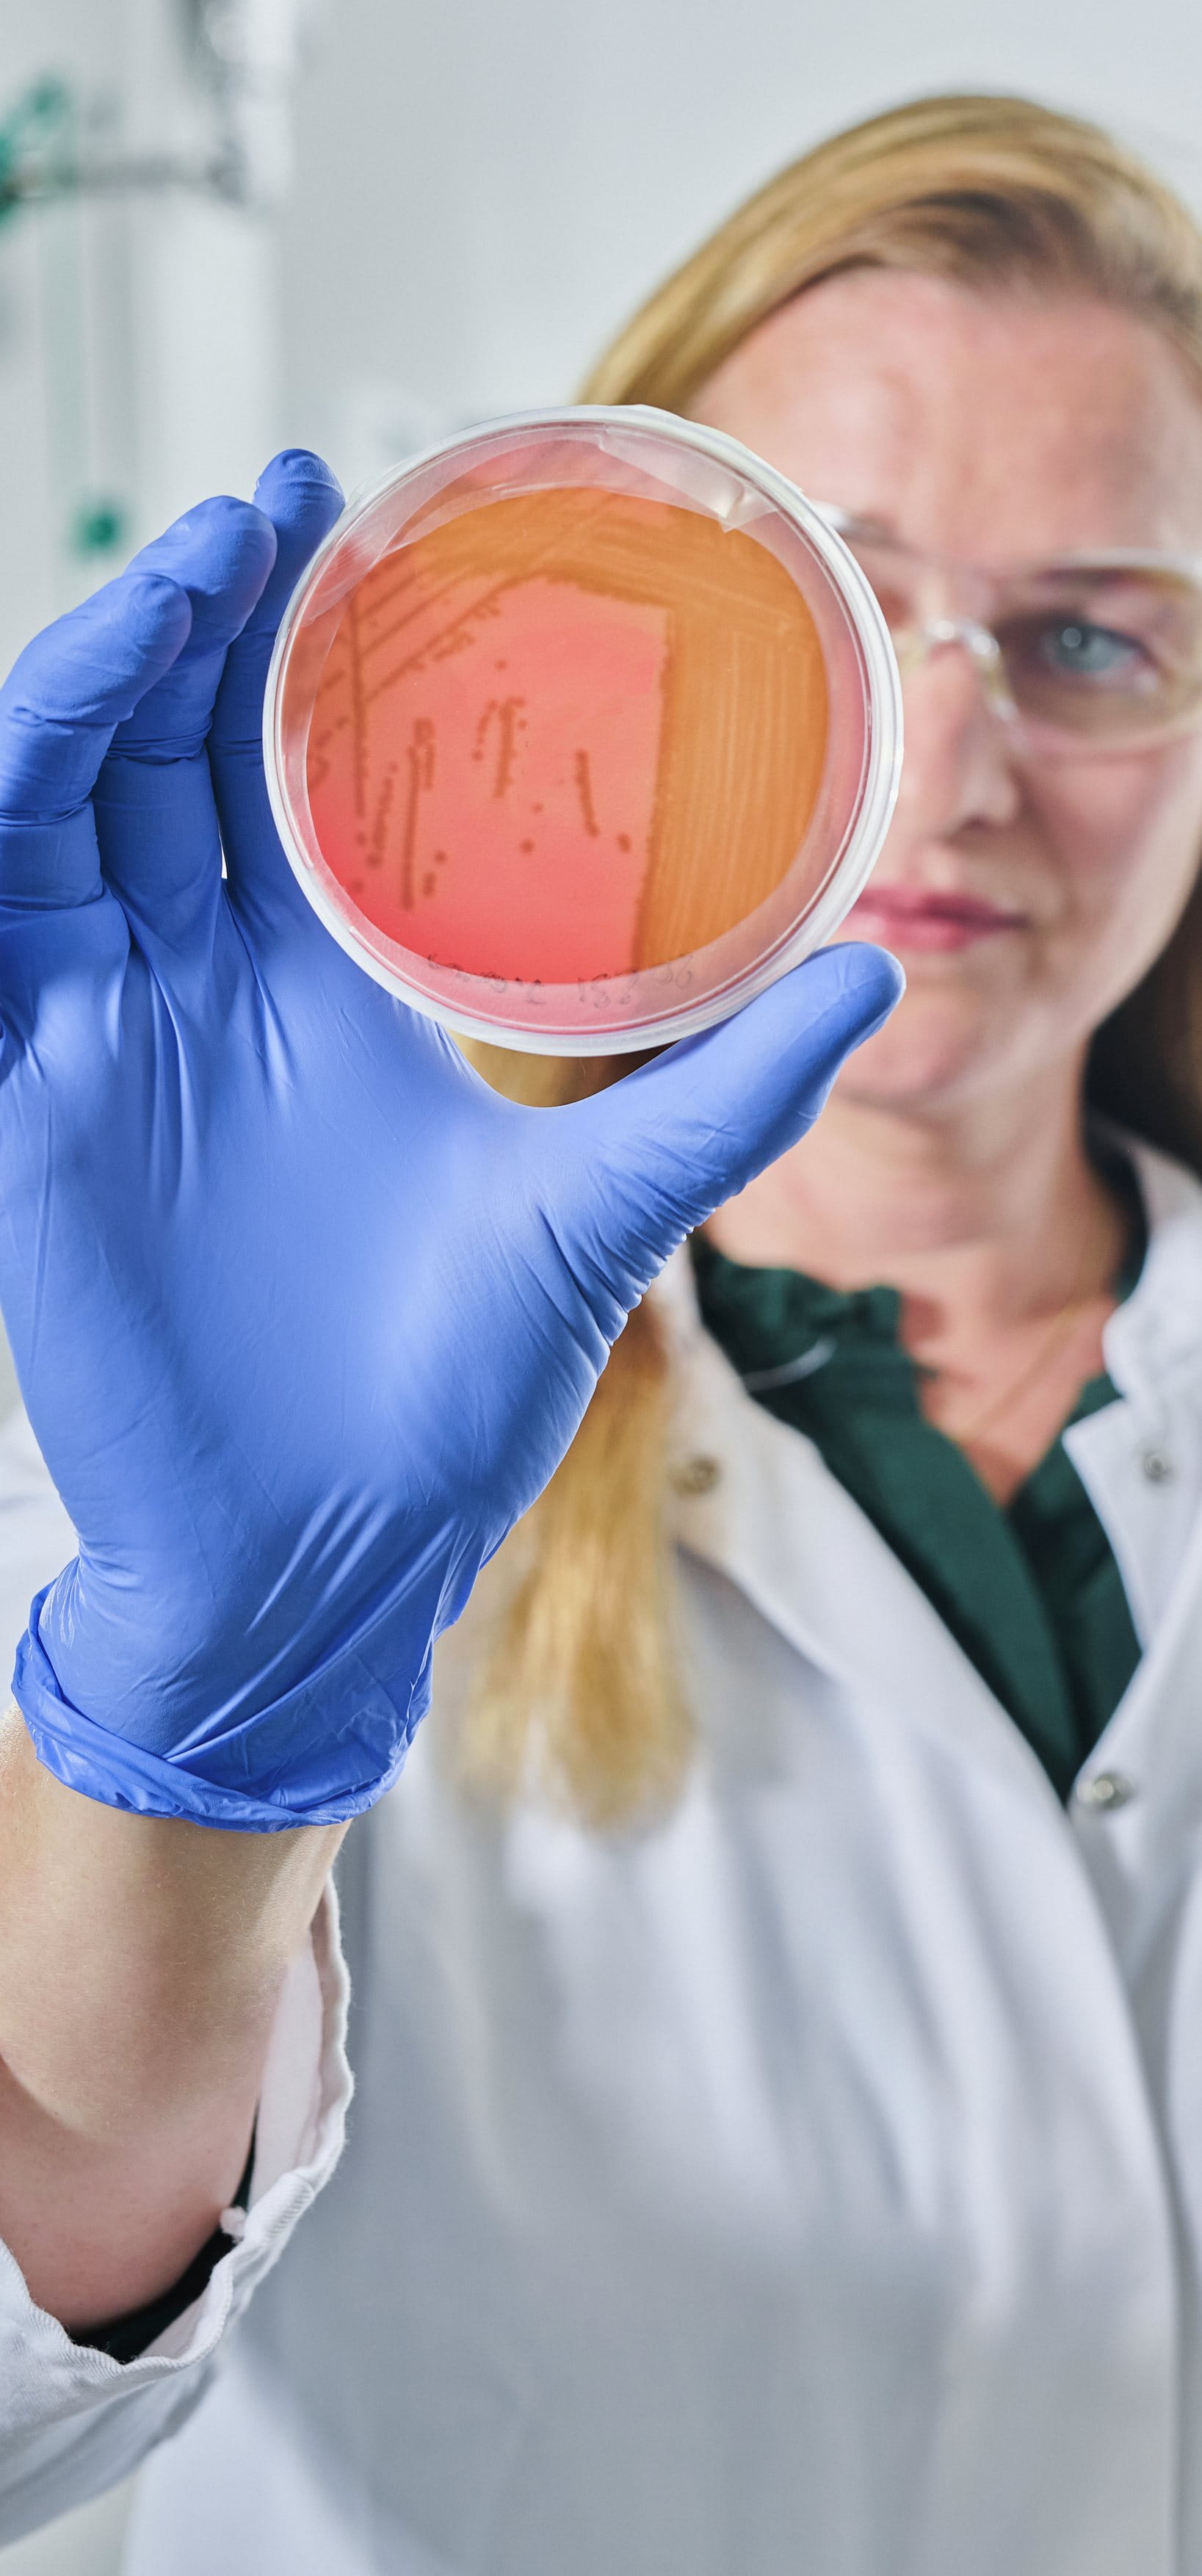

Unsere Haut ist mit einer Fläche von rund zwei Quadratmetern unser größtes Organ. Milliarden von Mikroorganismen leben in Symbiose mit ihr und bilden das Hautmikrobiom. Das Mikrobiom wirkt wie ein intelligenter Schutzschild gegen äußere Einflüsse. Doch das Gleichgewicht ist entscheidend: Eine Überbesiedelung mit bestimmten Mikroorganismen kann die Zusammensetzung stören und sich im Hautzustand widerspiegeln. Hautprobleme können auftreten. Deshalb ist es wichtig, das Hautmikrobiom und seine bakterielle Vielfalt wieder ins Gleichgewicht zu bringen. Genau hier setzen wir an: Mit unserem Know-how in der Mikrobiomforschung entwickeln wir innovative Hautpflegelösungen, die die Pflege der Haut neu definieren – wissenschaftlich fundiert und wirksam.